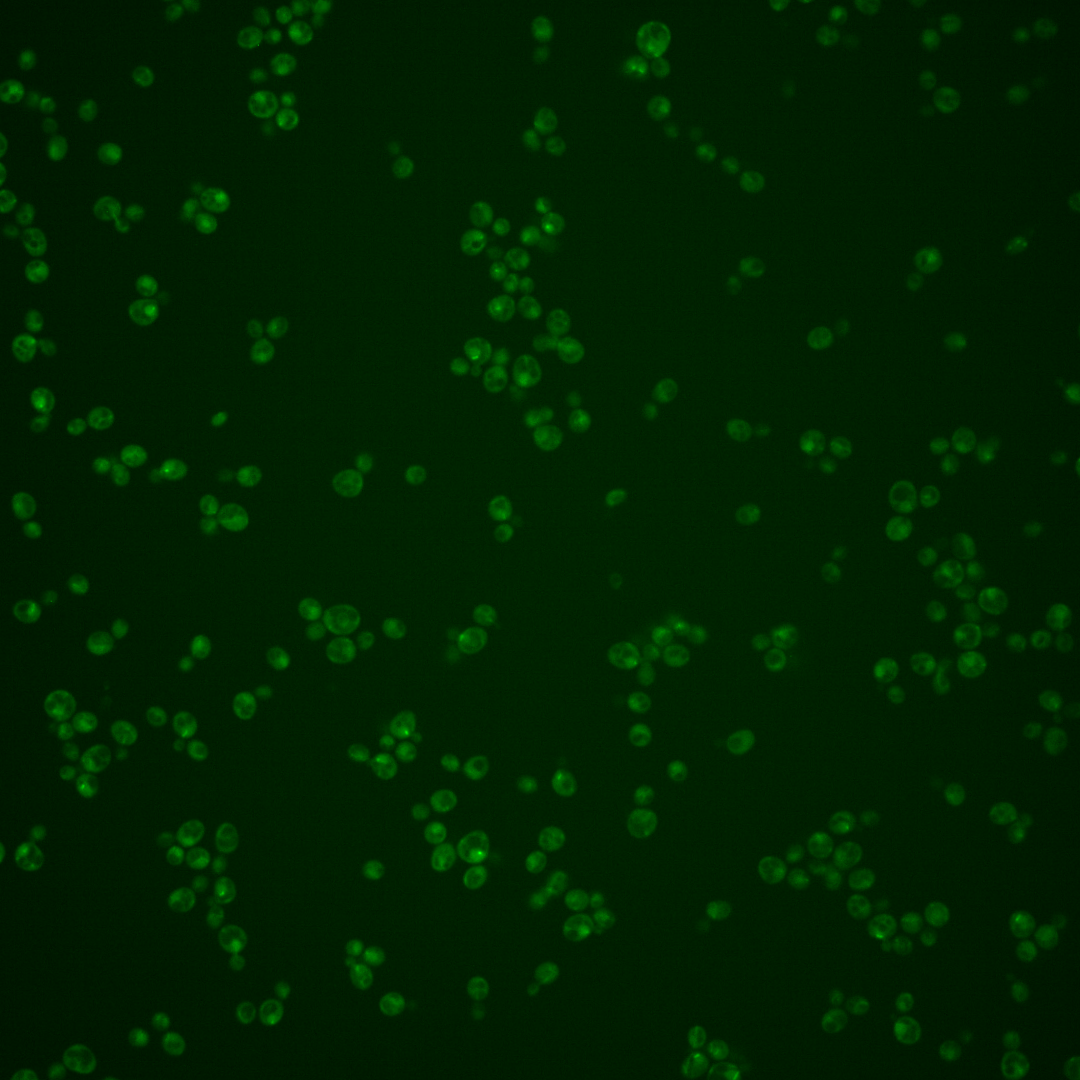
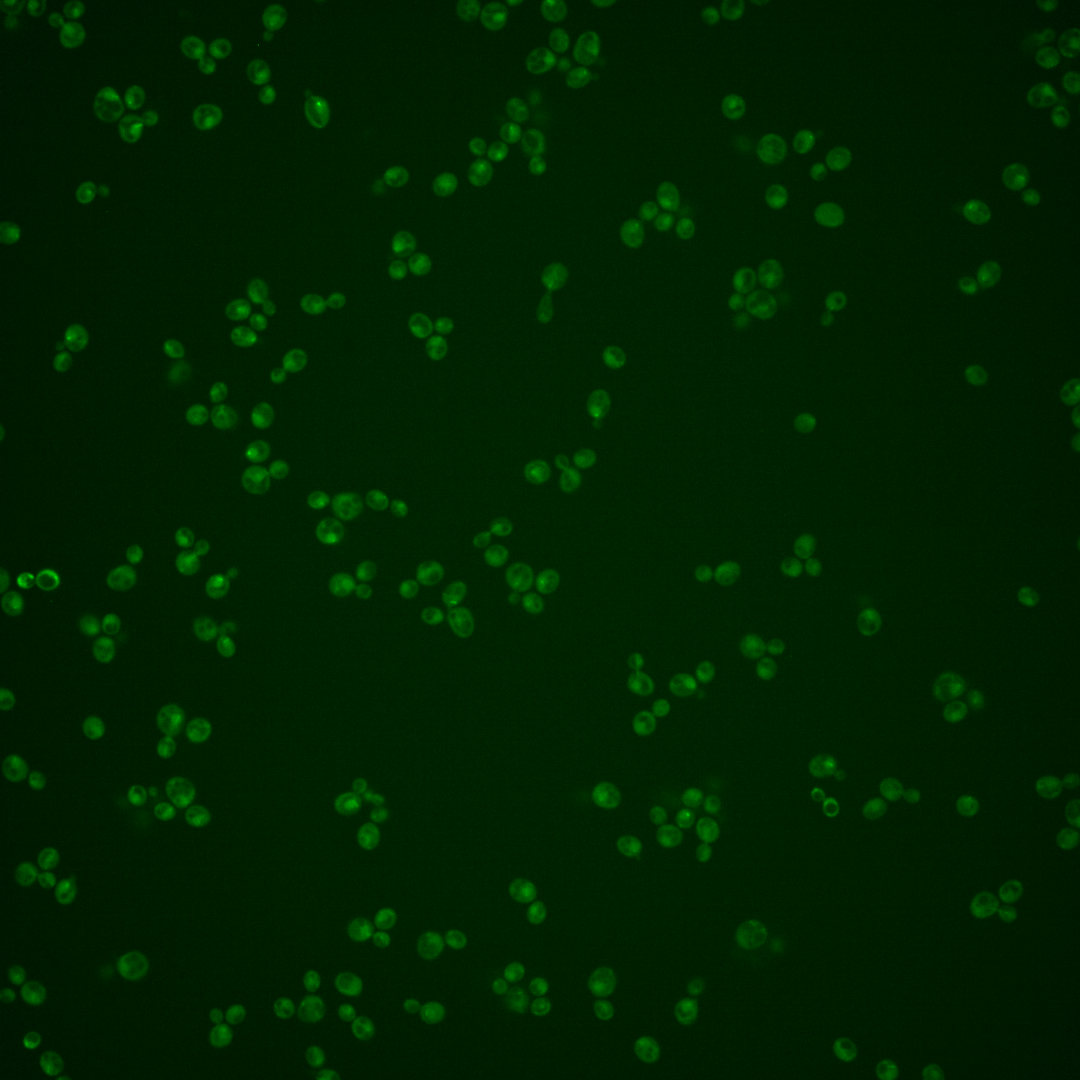
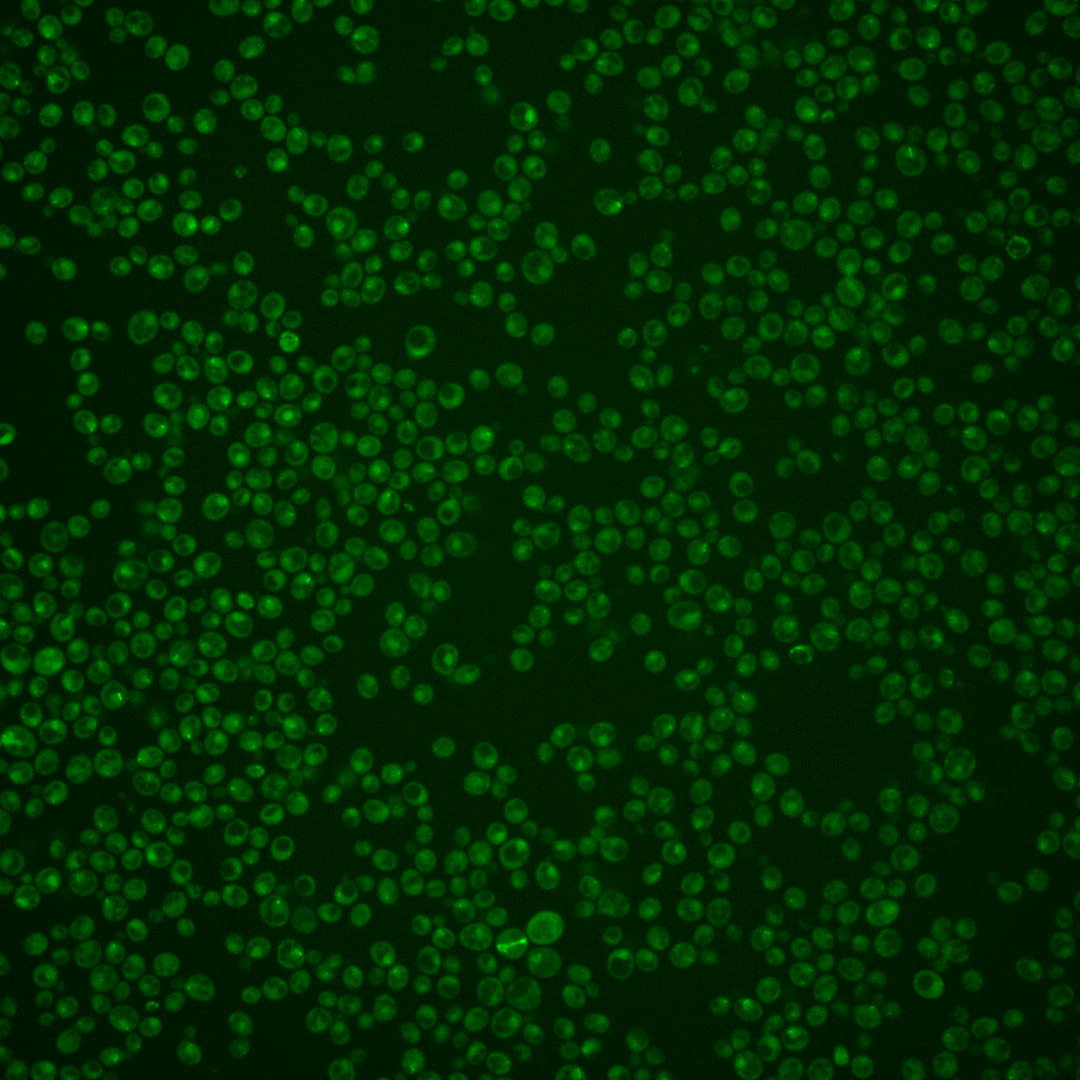
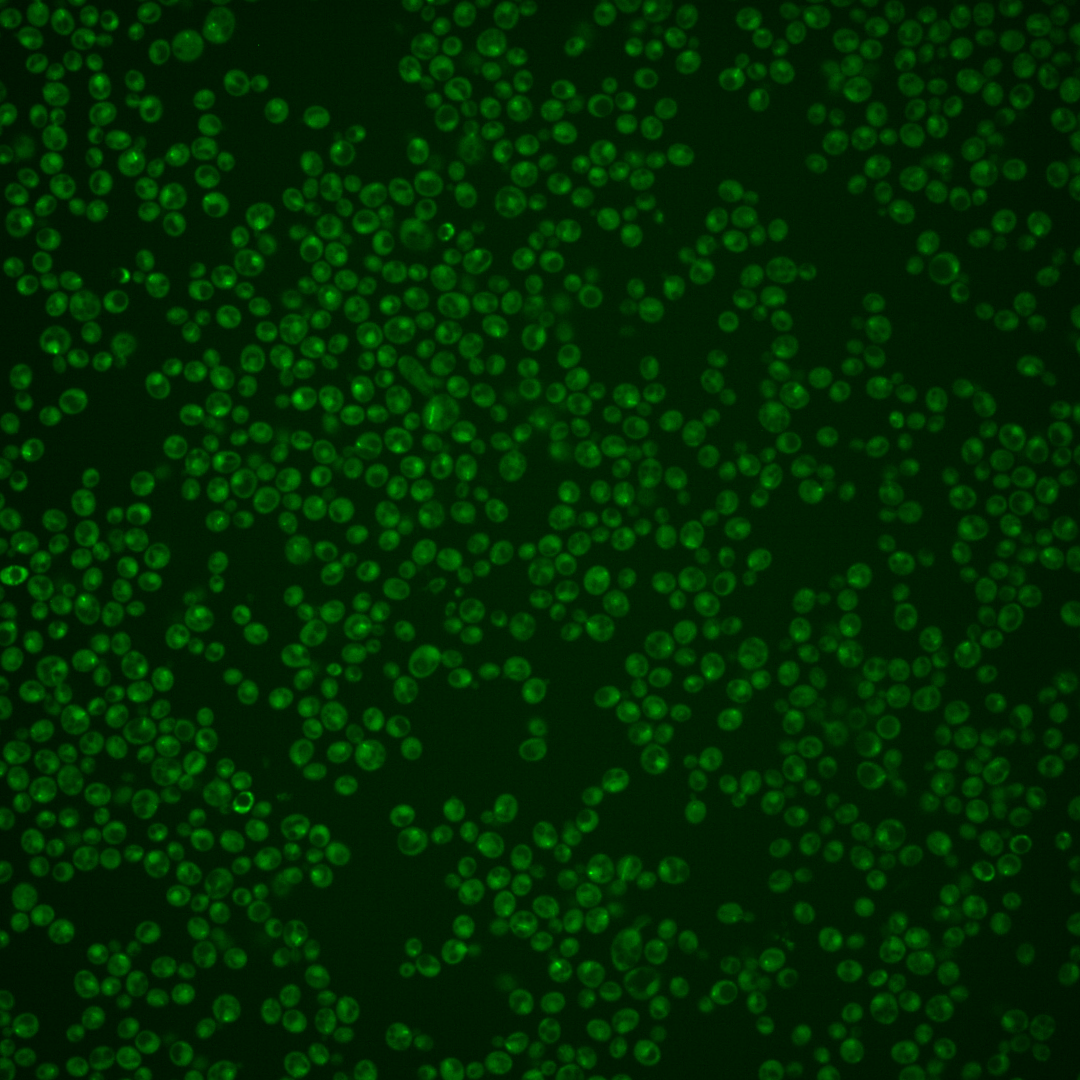

| Standard name | |
|---|---|
| Human Ortholog | |
| Description | Mitotic spindle protein; interacts with components of the Dam1 (DASH) complex, its effector Sli15p, and microtubule-associated protein Bim1p; also localizes to nuclear microtubules and to the bud neck in a ring-shaped structure; inhibits dynein function |
Micrographs




















































































Sub-cellular Localization
Yeast GFP Assignment
Protein Abundance
Localization Change
External localization resources
| ensLOC | DeepLoc | |||||||||||||||||||||||
|---|---|---|---|---|---|---|---|---|---|---|---|---|---|---|---|---|---|---|---|---|---|---|---|---|
| Localization | WT1 | WT2 | WT3 | RAP60 | RAP140 | RAP220 | RAP300 | RAP380 | RAP460 | RAP540 | RAP620 | RAP700 | HU80 | HU120 | HU160 | rpd3Δ_1 | rpd3Δ_2 | rpd3Δ_3 | WT1 | WT2 | WT3 | AF100 | AF140 | AF180 |
| Cortical Patches | 0 | 0 | 2 | 0 | 1 | 0 | 1 | 0 | 0 | 0 | 0 | 0 | 1 | 0 | 0 | 0 | 0 | 0 | 2 | 3 | 1 | 5 | 9 | 16 |
| Bud | 1 | 1 | 2 | 7 | 0 | 6 | 12 | 18 | 21 | 18 | 14 | 8 | 1 | 1 | 0 | 0 | 2 | 2 | 2 | 4 | 2 | 2 | 10 | 16 |
| Bud Neck | 0 | 1 | 20 | 15 | 23 | 6 | 9 | 26 | 8 | 12 | 4 | 12 | 10 | 6 | 2 | 0 | 0 | 0 | 1 | 2 | 2 | 1 | 4 | 10 |
| Bud Site | 0 | 0 | 0 | 1 | 0 | 0 | 12 | 6 | 10 | 14 | 14 | 5 | 0 | 0 | 0 | 1 | 4 | 4 | – | – | – | – | – | – |
| Cell Periphery | 0 | 0 | 0 | 0 | 0 | 0 | 0 | 1 | 0 | 0 | 0 | 0 | 0 | 0 | 1 | 1 | 1 | 0 | 0 | 0 | 0 | 0 | 1 | 1 |
| Cytoplasm | 68 | 58 | 118 | 129 | 166 | 164 | 154 | 186 | 148 | 206 | 81 | 124 | 122 | 249 | 248 | 52 | 47 | 75 | 55 | 35 | 68 | 86 | 126 | 150 |
| Endoplasmic Reticulum | 0 | 4 | 2 | 0 | 1 | 0 | 0 | 0 | 0 | 0 | 0 | 3 | 2 | 1 | 3 | 11 | 12 | 15 | 1 | 0 | 1 | 1 | 2 | 4 |
| Endosome | 12 | 31 | 4 | 14 | 39 | 19 | 12 | 15 | 13 | 9 | 4 | 11 | 27 | 74 | 84 | 143 | 107 | 184 | 11 | 22 | 22 | 25 | 36 | 19 |
| Golgi | 1 | 0 | 0 | 0 | 0 | 0 | 0 | 0 | 0 | 0 | 0 | 0 | 0 | 1 | 0 | 1 | 1 | 2 | 0 | 2 | 0 | 0 | 1 | 3 |
| Mitochondria | 61 | 10 | 1 | 16 | 20 | 79 | 175 | 151 | 242 | 224 | 228 | 175 | 2 | 0 | 0 | 8 | 15 | 23 | 26 | 20 | 43 | 33 | 54 | 56 |
| Nucleus | 3 | 8 | 4 | 1 | 6 | 12 | 12 | 16 | 12 | 19 | 15 | 16 | 7 | 6 | 3 | 22 | 11 | 12 | 2 | 8 | 3 | 2 | 1 | 0 |
| Nuclear Periphery | 0 | 0 | 0 | 1 | 0 | 0 | 0 | 0 | 0 | 0 | 0 | 0 | 0 | 0 | 0 | 0 | 1 | 1 | 1 | 1 | 0 | 0 | 3 | 1 |
| Nucleolus | 7 | 4 | 0 | 1 | 1 | 1 | 9 | 2 | 2 | 5 | 5 | 4 | 6 | 0 | 1 | 40 | 56 | 100 | 2 | 5 | 3 | 2 | 2 | 0 |
| Peroxisomes | 0 | 0 | 0 | 2 | 2 | 4 | 1 | 0 | 1 | 0 | 1 | 3 | 1 | 5 | 6 | 3 | 0 | 9 | 1 | 0 | 1 | 0 | 2 | 1 |
| SpindlePole | 20 | 10 | 70 | 77 | 108 | 65 | 68 | 114 | 59 | 73 | 36 | 47 | 40 | 77 | 36 | 173 | 132 | 186 | 66 | 47 | 114 | 105 | 125 | 117 |
| Vac/Vac Membrane | 16 | 22 | 8 | 4 | 19 | 12 | 6 | 20 | 23 | 13 | 11 | 22 | 9 | 31 | 26 | 53 | 31 | 48 | 19 | 14 | 12 | 7 | 12 | 13 |
| Unique Cell Count | 160 | 129 | 215 | 239 | 339 | 318 | 383 | 459 | 424 | 468 | 313 | 348 | 204 | 399 | 368 | 352 | 270 | 419 | 212 | 179 | 297 | 293 | 413 | 432 |
| Labelled Cell Count | 189 | 149 | 231 | 268 | 386 | 368 | 471 | 555 | 539 | 593 | 413 | 430 | 228 | 451 | 410 | 508 | 420 | 661 | 212 | 179 | 297 | 293 | 413 | 432 |
Yeast GFP Assignment
Protein Abundance
| Screen | WT1 | WT2 | WT3 | RAP60 | RAP140 | RAP220 | RAP300 | RAP380 | RAP460 | RAP540 | RAP620 | RAP700 | HU80 | HU120 | HU160 | rpd3Δ_1 | rpd3Δ_2 | rpd3Δ_3 | AF100 | AF140 | AF180 |
|---|---|---|---|---|---|---|---|---|---|---|---|---|---|---|---|---|---|---|---|---|---|
| Mean Cell GFP Intensity (1e-4) | 3.5 | 4.7 | 5.0 | 4.8 | 4.6 | 3.9 | 3.6 | 4.1 | 3.7 | 3.6 | 3.3 | 3.7 | 4.9 | 5.3 | 5.4 | 6.8 | 6.1 | 5.8 | 4.9 | 5.1 | 5.7 |
| Std Deviation (1e-4) | 0.6 | 0.9 | 1.0 | 2.0 | 1.2 | 1.7 | 1.6 | 1.1 | 2.2 | 1.2 | 0.8 | 0.8 | 1.4 | 1.4 | 1.4 | 1.1 | 1.2 | 1.2 | 1.4 | 1.8 | 2.4 |
| Intensity Change (Log2) | – | – | – | -0.05 | -0.12 | -0.35 | -0.46 | -0.28 | -0.44 | -0.45 | -0.61 | -0.44 | -0.03 | 0.08 | 0.11 | 0.45 | 0.29 | 0.21 | -0.03 | 0.02 | 0.2 |
Localization Change
| Localization | RAP60 | RAP140 | RAP220 | RAP300 | RAP380 | RAP460 | RAP540 | RAP620 | RAP700 | HU80 | HU120 | HU160 | rpd3Δ_1 | rpd3Δ_2 | rpd3Δ_3 |
|---|---|---|---|---|---|---|---|---|---|---|---|---|---|---|---|
| Actin | – | – | – | – | – | – | – | – | – | – | – | – | – | – | – |
| Bud | – | – | – | – | – | – | – | – | – | – | – | – | 0 | 0 | 0 |
| Bud Neck | – | – | – | – | – | – | – | – | – | – | – | – | 0 | 0 | 0 |
| Bud Site | – | – | – | – | – | – | – | – | – | – | – | – | 0 | 0 | 0 |
| Cell Periphery | – | – | – | – | – | – | – | – | – | – | – | – | 0 | 0 | 0 |
| Cyto | – | – | – | – | – | – | – | – | – | – | – | – | – | – | – |
| Endoplasmic Reticulum | – | – | – | – | – | – | – | – | – | – | – | – | 0 | 0 | 0 |
| Endosome | – | – | – | – | – | – | – | – | – | – | – | – | 0 | 0 | 0 |
| Golgi | – | – | – | – | – | – | – | – | – | – | – | – | 0 | 0 | 0 |
| Mitochondria | – | – | – | – | – | – | – | – | – | – | – | – | 0 | 0 | 0 |
| Nuclear Periphery | – | – | – | – | – | – | – | – | – | – | – | – | 0 | 0 | 0 |
| Nuc | – | – | – | – | – | – | – | – | – | – | – | – | – | – | – |
| Nucleolus | – | – | – | – | – | – | – | – | – | – | – | – | 0 | 0 | 0 |
| Peroxisomes | – | – | – | – | – | – | – | – | – | – | – | – | 0 | 0 | 0 |
| SpindlePole | – | – | – | – | – | – | – | – | – | – | – | – | 0 | 0 | 0 |
| Vac | – | – | – | – | – | – | – | – | – | – | – | – | – | – | – |
| Cortical Patches | – | – | – | – | – | – | – | – | – | – | – | – | 0 | 0 | 0 |
| Cytoplasm | – | – | – | – | – | – | – | – | – | – | – | – | 0 | 0 | 0 |
| Nucleus | – | – | – | – | – | – | – | – | – | – | – | – | 0 | 0 | 0 |
| Vacuole | – | – | – | – | – | – | – | – | – | – | – | – | 4.2 | 3.1 | 3.2 |
External localization resources
Images






























Protein Concentration and Protein Localization Data
| R1 | R2 | R3 | ||||||||||||||||
|---|---|---|---|---|---|---|---|---|---|---|---|---|---|---|---|---|---|---|
| G1 Pre-START | G1 Post-START | S/G2 | Metaphase | Anaphase | Telophase | G1 Pre-START | G1 Post-START | S/G2 | Metaphase | Anaphase | Telophase | G1 Pre-START | G1 Post-START | S/G2 | Metaphase | Anaphase | Telophase | |
| Concentration | 0.0891 | -0.4304 | -0.2063 | -0.3544 | -0.5975 | -0.3538 | 0.1717 | -0.4908 | -0.402 | -0.1567 | -0.5933 | -0.085 | -0.8354 | -0.5923 | -0.5295 | -0.0675 | -0.4599 | -0.6536 |
| Actin | 0.0243 | 0.0009 | 0.0086 | 0.0347 | 0.0152 | 0.0147 | 0.0212 | 0.001 | 0.0038 | 0.0029 | 0.0018 | 0.0015 | 0.0121 | 0.0008 | 0.0097 | 0.0145 | 0.0048 | 0.0039 |
| Bud | 0.0007 | 0.0007 | 0.0006 | 0.0117 | 0.0006 | 0.0039 | 0.0016 | 0.0002 | 0.0001 | 0.0004 | 0.0003 | 0.0001 | 0.0006 | 0.0003 | 0.0002 | 0.0007 | 0.0011 | 0.0003 |
| Bud Neck | 0.0065 | 0.0015 | 0.0036 | 0.0025 | 0.0013 | 0.0023 | 0.02 | 0.001 | 0.0014 | 0.0015 | 0.0019 | 0.0039 | 0.0025 | 0.0015 | 0.0017 | 0.0038 | 0.0022 | 0.0041 |
| Bud Periphery | 0.0009 | 0.0008 | 0.0008 | 0.0029 | 0.0016 | 0.0057 | 0.0045 | 0.0003 | 0.0002 | 0.0007 | 0.0006 | 0.0001 | 0.0006 | 0.0003 | 0.0002 | 0.0008 | 0.001 | 0.0003 |
| Bud Site | 0.0032 | 0.0109 | 0.0172 | 0.0029 | 0.0013 | 0.0008 | 0.0168 | 0.0021 | 0.0009 | 0.0017 | 0.0009 | 0.0003 | 0.0023 | 0.0038 | 0.0045 | 0.0076 | 0.0014 | 0.0007 |
| Cell Periphery | 0.0002 | 0.0002 | 0.0008 | 0.0006 | 0.0001 | 0.0001 | 0.0009 | 0.0001 | 0 | 0 | 0.0001 | 0 | 0.0001 | 0.0001 | 0.0001 | 0.0001 | 0.0001 | 0.0001 |
| Cytoplasm | 0.0834 | 0.1375 | 0.0859 | 0.0829 | 0.1078 | 0.126 | 0.0775 | 0.1071 | 0.0381 | 0.0803 | 0.162 | 0.1053 | 0.0705 | 0.1025 | 0.0657 | 0.0747 | 0.1443 | 0.1091 |
| Cytoplasmic Foci | 0.0597 | 0.033 | 0.0234 | 0.0172 | 0.0299 | 0.0293 | 0.0674 | 0.0396 | 0.0294 | 0.0313 | 0.017 | 0.0194 | 0.0463 | 0.0263 | 0.0345 | 0.0178 | 0.0158 | 0.0224 |
| Eisosomes | 0.0002 | 0.0001 | 0.0004 | 0.0007 | 0.0002 | 0.0002 | 0.0007 | 0.0001 | 0.0001 | 0.0001 | 0.0001 | 0.0001 | 0.0001 | 0.0001 | 0.0001 | 0.0001 | 0.0001 | 0.0005 |
| Endoplasmic Reticulum | 0.016 | 0.0039 | 0.0048 | 0.0048 | 0.002 | 0.003 | 0.0053 | 0.0023 | 0.0009 | 0.0021 | 0.003 | 0.0012 | 0.0029 | 0.0026 | 0.0024 | 0.0029 | 0.004 | 0.0021 |
| Endosome | 0.0498 | 0.0094 | 0.0194 | 0.0204 | 0.0354 | 0.0093 | 0.0357 | 0.0073 | 0.0061 | 0.0098 | 0.0354 | 0.007 | 0.0166 | 0.0095 | 0.0097 | 0.0135 | 0.0315 | 0.0088 |
| Golgi | 0.0076 | 0.0007 | 0.0068 | 0.0044 | 0.0075 | 0.0012 | 0.0064 | 0.0006 | 0.0015 | 0.0031 | 0.0071 | 0.0009 | 0.0034 | 0.0006 | 0.0015 | 0.003 | 0.0041 | 0.0016 |
| Lipid Particles | 0.0221 | 0.005 | 0.0074 | 0.0061 | 0.0157 | 0.0067 | 0.0235 | 0.0029 | 0.0057 | 0.0073 | 0.0168 | 0.0078 | 0.012 | 0.0031 | 0.0045 | 0.0206 | 0.0109 | 0.0028 |
| Mitochondria | 0.0052 | 0.0012 | 0.0084 | 0.033 | 0.0049 | 0.0019 | 0.024 | 0.0012 | 0.0127 | 0.0656 | 0.005 | 0.0011 | 0.0052 | 0.0013 | 0.0012 | 0.004 | 0.0138 | 0.0012 |
| None | 0.4012 | 0.4515 | 0.378 | 0.279 | 0.5452 | 0.3834 | 0.2814 | 0.3295 | 0.1564 | 0.2508 | 0.3033 | 0.3573 | 0.2284 | 0.2664 | 0.1156 | 0.2464 | 0.1894 | 0.2176 |
| Nuclear Periphery | 0.0514 | 0.0135 | 0.0138 | 0.0305 | 0.0113 | 0.0286 | 0.0259 | 0.0159 | 0.0173 | 0.0247 | 0.0316 | 0.0177 | 0.0206 | 0.0198 | 0.0223 | 0.0189 | 0.0377 | 0.0154 |
| Nucleolus | 0.0062 | 0.0092 | 0.0136 | 0.0107 | 0.0048 | 0.0072 | 0.0086 | 0.0102 | 0.0148 | 0.0044 | 0.0055 | 0.0141 | 0.0085 | 0.0112 | 0.0091 | 0.0196 | 0.0097 | 0.0117 |
| Nucleus | 0.0414 | 0.1162 | 0.0988 | 0.2414 | 0.1104 | 0.1271 | 0.0659 | 0.1331 | 0.135 | 0.0704 | 0.2307 | 0.1993 | 0.1366 | 0.2175 | 0.1652 | 0.1243 | 0.2506 | 0.2229 |
| Peroxisomes | 0.0152 | 0.0014 | 0.0034 | 0.0027 | 0.0091 | 0.0069 | 0.0253 | 0.0044 | 0.0145 | 0.0116 | 0.0176 | 0.0049 | 0.0156 | 0.0015 | 0.0029 | 0.0127 | 0.0129 | 0.0014 |
| Punctate Nuclear | 0.1977 | 0.1991 | 0.2997 | 0.2043 | 0.0919 | 0.2372 | 0.2804 | 0.3392 | 0.5599 | 0.43 | 0.1542 | 0.2565 | 0.4124 | 0.3271 | 0.547 | 0.412 | 0.2592 | 0.3717 |
| Vacuole | 0.0045 | 0.0027 | 0.0036 | 0.0047 | 0.0031 | 0.0031 | 0.0048 | 0.0016 | 0.0008 | 0.0007 | 0.0035 | 0.0009 | 0.0021 | 0.0027 | 0.0014 | 0.0015 | 0.0038 | 0.001 |
| Vacuole Periphery | 0.0027 | 0.0005 | 0.0008 | 0.0018 | 0.0008 | 0.0014 | 0.0021 | 0.0003 | 0.0003 | 0.0005 | 0.0018 | 0.0004 | 0.0007 | 0.0009 | 0.0006 | 0.0007 | 0.0017 | 0.0004 |
Sequencing Data
| R1 | R2 | |||||||||
|---|---|---|---|---|---|---|---|---|---|---|
| G1 Post-START | S/G2 | Metaphase | Anaphase | Telophase | G1 Post-START | S/G2 | Metaphase | Anaphase | Telophase | |
| Gene Expression | 14.647 | 7.7591 | 1.4394 | 7.408 | 12.6603 | 13.0123 | 10.7872 | 8.9353 | 6.9099 | 15.6895 |
| Translational Efficiency | – | – | – | – | – | – | – | – | – | – |
Hit Data
| Dataset | Hit |
|---|---|
| Protein Concentration | ✘ |
| Protein Localization | ✘ |
| Gene Expression | ✔ |
| Translational Efficiency | – |
Endocytosis
| Temp | Actin Patch (Sac6-tdTomato) | Cortical Patch (Sla1-GFP) | Late Endosome (Snf7-GFP) | Vacuole (Vph1-GFP) |
|---|---|---|---|---|
| 37℃ | ||||
| RT |
Cell Cycle Omics
CYCLoPs (She1-GFP)
| Gene / Allele | Actin Patch (Sac6-tdTomato) | Cortical Patch (Sla1-GFP) | Late Endosome (Snf7-GFP) | Vacuole (Sac6-tdTomato) |
|---|
| Gene | Images |
|---|
| Gene | Images |
|---|
Images are not yet available
Images are not yet available